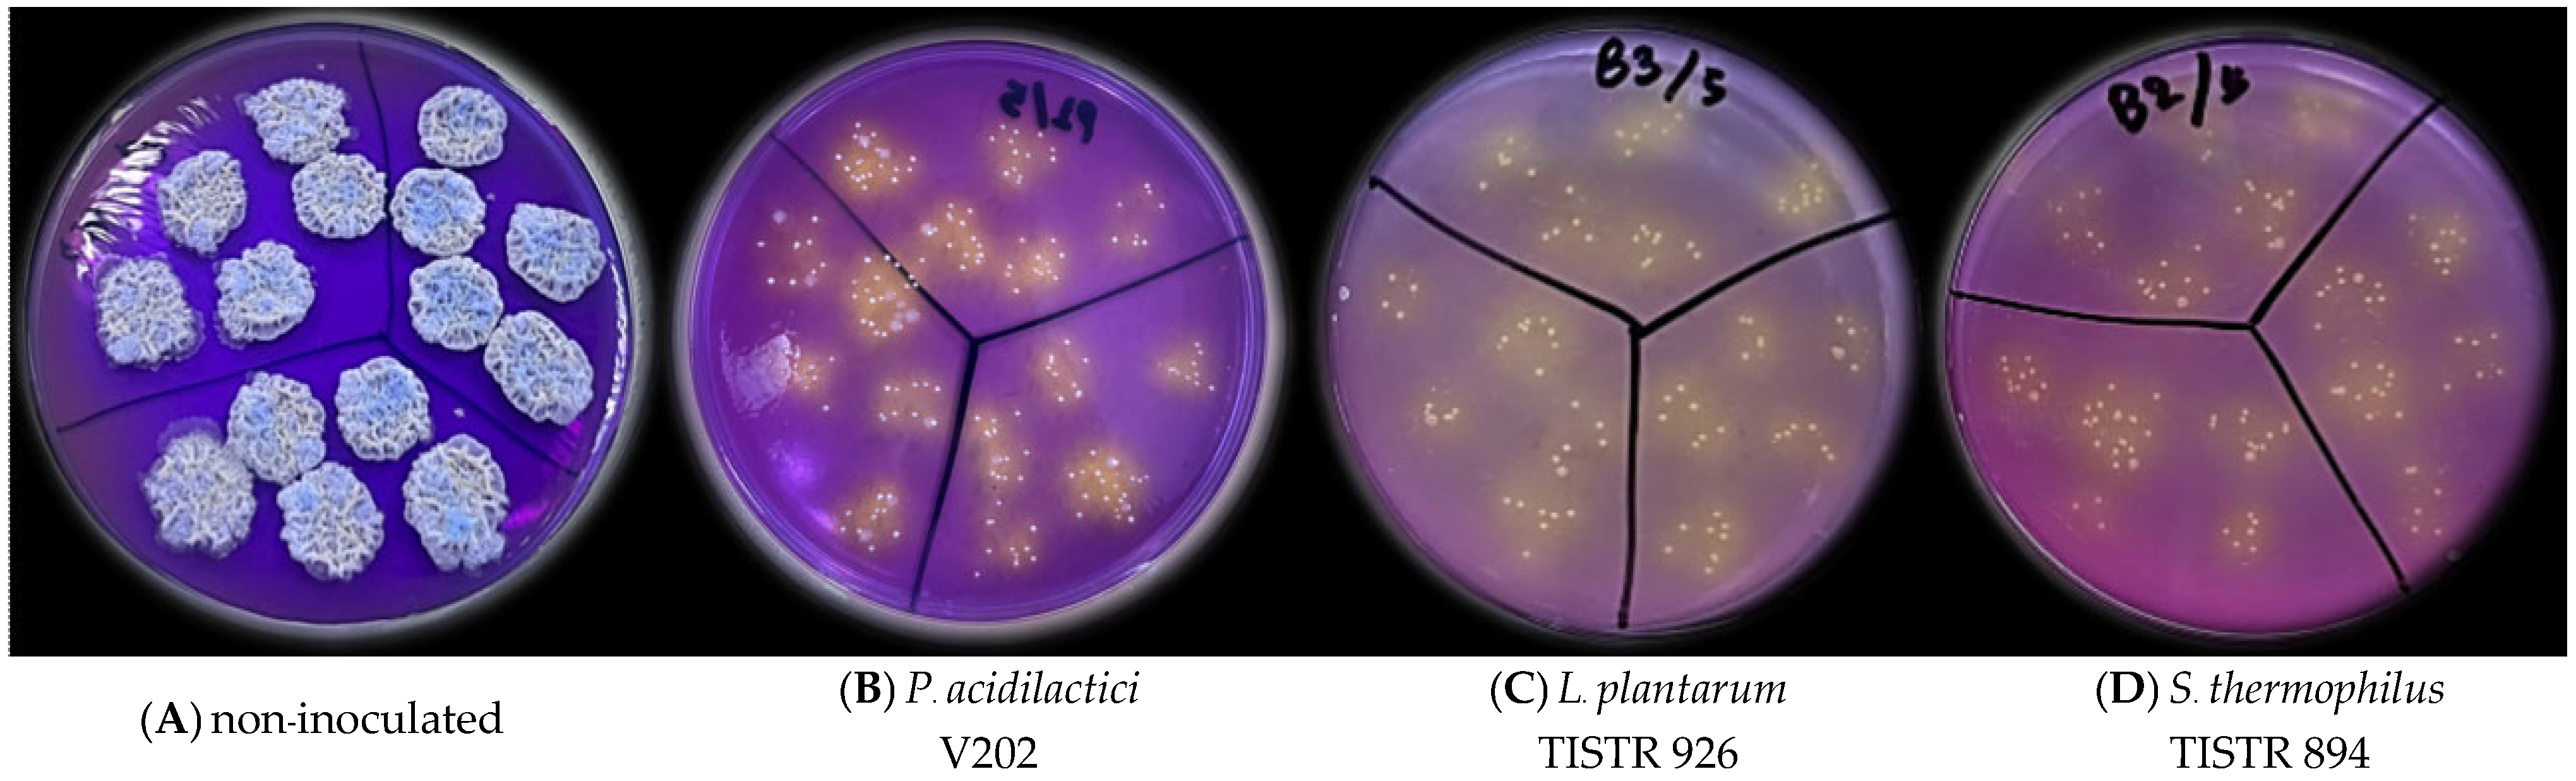

Optimization of Tiliacora triandra Leaf Extraction and Probiotic Fermentation for Developing a Functional Freeze-Dried Feed Supplements
Abstract
1. Introduction
2. Materials and Methods
2.1. Experiment 1: Extraction Optimal Conditions for Yanang Leaf Extract for Use as a Natural Medium for P. acidilactici V202 Fermentation
2.1.1. Experimental Design and Fermentation Procedure
- (1)
- Leaf freezing (unfrozen or frozen at −20 °C);
- (2)
- Leaf blanching (unblanched or blanched by immersion in boiling water for 2 min);
- (3)
- Leaf preparation process (unfrozen and unblanched leaves, frozen and unblenched leaves, frozen first, then blanched leaves, blanched leaves and unfrozen, and blanched first, then frozen leaves);
- (4)
- Leaf-to-water ratio (1:3, 1:4, or 1:5 w/v);
- (5)
- Water temperature during extraction (4 °C, 25 °C, or 100 °C);
- (6)
- Heat sterilization (no sterilization [control], pasteurization at 75 °C for 5 min, steam sterilization at 100 °C for 10 min, or autoclaving at 121 °C for 15 min).
2.1.2. Fermentation and Determination of pH, Total Soluble Solids, and Viable Counts
2.1.3. Statistical Analysis
2.2. Experiment 2: Probiotic Fermentation Using Yanang Leaf Extract as a Natural Medium and Production of Freeze-Dried Probiotics
2.2.1. Experimental Design
2.2.2. Yanang Leaf Extract Preparation Under Optimal Conditions
2.2.3. Determination of Yield, Product Quality, and Stability
2.2.4. Determination of Minimal Inhibitory Concentration (MIC) and Minimal Bactericidal Concentration (MBC)
2.2.5. Statistical Analysis
3. Result and Discussion
3.1. Experiment 1: Extraction Optimal Conditions for Yanang Leaf Extract for Use as a Natural Medium for P. acidilactici V202 Fermentation
3.2. Experiment 2: Probiotic Fermentation Using Yanang Leaf Extract as a Natural Medium and Production of Freeze-Dried Probiotics
4. Conclusions
Author Contributions
Funding
Institutional Review Board Statement
Informed Consent Statement
Data Availability Statement
Acknowledgments
Conflicts of Interest
References
- Theodoridou Oxinou, D.; Lamnisos, D.; Filippou, C.; Spernovasilis, N.; Tsioutis, C. Antimicrobial Use and Antimicrobial Resistance in Food-Producing Animals: Cross-Sectional Study on Knowledge, Attitudes, and Practices Among Veterinarians and Operators of Establishments in the Republic of Cyprus. Antibiotics 2025, 14, 251. [Google Scholar] [CrossRef]
- Abreu, R.; Semedo-Lemsaddek, T.; Cunha, E.; Tavares, L.; Oliveira, M. Antimicrobial Drug Resistance in Poultry Production: Current Status and Innovative Strategies for Bacterial Control. Microorganisms 2023, 11, 953. [Google Scholar] [CrossRef]
- Bungsrisawat, P.; Tunseng, S.; Kiatsomphob, S.; Prasongsook, S.; Bunchasak, C.; Rakangthong, C. Comparing Commercial and Slow-Growing Broilers in Thailand: Growth, Carcass Quality, Economics, and Environmental Perspective. Poult. Sci. 2025, 104, 104880. [Google Scholar] [CrossRef] [PubMed]
- Shehata, A.A.; Yalçın, S.; Latorre, J.D.; Basiouni, S.; Attia, Y.A.; Abd El-Wahab, A.; Visscher, C.; El-Seedi, H.R.; Huber, C.; Hafez, H.M.; et al. Probiotics, Prebiotics, and Phytogenic Substances for Optimizing Gut Health in Poultry. Microorganisms 2022, 10, 395. [Google Scholar] [CrossRef] [PubMed]
- Rachwał, K.; Gustaw, K. Plant-Derived Phytobiotics as Emerging Alternatives to Antibiotics Against Foodborne Pathogens. Appl. Sci. 2025, 15, 6774. [Google Scholar] [CrossRef]
- Dhiman, S.; Kaur, S.; Thakur, B.; Singh, P.; Tripathi, M. Nutritional Enhancement of Plant-Based Fermented Foods: Microbial Innovations for a Sustainable Future. Fermentation 2025, 11, 346. [Google Scholar] [CrossRef]
- Paventi, G.; Di Martino, C.; Coppola, F.; Iorizzo, M. β-Glucosidase Activity of Lactiplantibacillus plantarum: A Key Player in Food Fermentation and Human Health. Foods 2025, 14, 1451. [Google Scholar] [CrossRef]
- Kwuansawat, T.; Sriplee, S.; Meelek, P.; Sujayanont, P. Comprehensive Antioxidant Evaluation of Tiliacora triandra Extracts: Assays of Leaf, Stem, and Root. Pharmacogn. J. 2025, 17, 95–98. [Google Scholar] [CrossRef]
- Nutmakul, T. Phytochemical and Pharmacological Activity of Tiliacora triandra (Colebr.) Diels. Songklanakarin J. Sci. Technol. 2021, 43, 1264–1274. [Google Scholar]
- Wann, C.; Wanapat, M.; Mapato, C.; Ampapon, T.; Huang, B. Effect of Bamboo Grass (Tiliacora triandra, Diels) Pellet Supplementation on Rumen Fermentation Characteristics and Methane Production in Thai Native Beef Cattle. Asian-Australas. J. Anim. Sci. 2019, 32, 1153–1160. [Google Scholar] [CrossRef]
- Singthong, J.; Oonsivilai, R. Structural and Rheological Properties of Yanang Gum (Tiliacora triandra). Foods 2022, 11, 2003. [Google Scholar] [CrossRef]
- Singthong, J.; Oonsivilai, R.; Oonmetta-aree, J.; Ningsanond, S. Bioactive Compounds and Encapsulation of Yanang (Tiliacora triandra) Leaves. Afr. J. Trad. Compl. Alt. Med. 2014, 11, 76. [Google Scholar] [CrossRef]
- Das, G.; Gouda, S.; Kerry, R.G.; Cortes, H.; Prado-Audelo, M.L.D.; Leyva-Gómez, G.; Tsouh Fokou, P.V.; Gutiérrez-Grijalva, E.P.; Heredia, J.B.; Shin, H.-S.; et al. Study of Traditional Uses, Extraction Procedures, Phytochemical Constituents, and Pharmacological Properties of Tiliacora triandra. J. Chem. 2022, 2022, 8754528. [Google Scholar] [CrossRef]
- Samankul, A.; Senawong, G.; Swatsitang, P.; Sripa, B.; Phaosiri, C.; Kanokmedhakul, S.; Senawong, T. Ethanolic Extract of Ya-Nang (Tiliacora triandra) Leaf Powder Induces Apoptosis in Cholangiocarcinoma Cell Lines via Induction of Hyperacetylation and Inhibition of Growth Signaling. PeerJ 2022, 10, e14518. [Google Scholar] [CrossRef] [PubMed]
- Manlapig, J.J.D.; Matsui, H. Production and Utilization of Fermented Rice Bran as Animal Feed. Anim. Sci. J. 2025, 96, e70037. [Google Scholar] [CrossRef] [PubMed]
- Ferronatto, A.N.; Rossi, R.; Massochin Nunes Pinto, L.; Garavaglia, J. Development of a Freeze-Dried Symbiotic Obtained from Rice Bran. Biotechnol. Rep. 2021, 30, e00636. [Google Scholar] [CrossRef]
- Poletto, G.; Fonseca, B.D.S.; Raddatz, G.C.; Wagner, R.; Lopes, E.J.; Barin, J.S.; Flores, E.M.D.M.; Menezes, C.R.D. Encapsulation of Lactobacillus acidophilus and Different Prebiotic Agents by External Ionic Gelation Followed by Freeze-Drying. Cienc. Rural. 2019, 49, e20180729. [Google Scholar] [CrossRef]
- Nilsang, P. Viability of the Microencapsulation of Lactobacillus casei TISTR 390 Containing Inulin in Simulated Gastrointestinal Conditions and Storage. Trends Sci. 2021, 18, 15. [Google Scholar] [CrossRef]
- Wichasit, S.; Phuangain, N.; Charoensook, R.; Likittrakulwong, W.; Incharoen, T.; Hwanhlem, N. Effect of drying temperature on the survival rate of rice bran-cultivated probiotic. Khon Kaen Agric. J. Suppl. 2024, 2, 515–520. (In Thai) [Google Scholar]
- Luft, L.; Mazutti, M.A. Freeze and Spray Drying Technologies to Produce Solid Microbial Formulations for Sustainable Agriculture. Processes 2025, 13, 2188. [Google Scholar] [CrossRef]
- Coşkun, N.; Sarıtaş, S.; Jaouhari, Y.; Bordiga, M.; Karav, S. The Impact of Freeze Drying on Bioactivity and Physical Properties of Food Products. Appl. Sci. 2024, 14, 9183. [Google Scholar] [CrossRef]
- Roy, A.; Khan, A.; Ahmad, I.; Alghamdi, S.; Rajab, B.S.; Babalghith, A.O.; Alshahrani, M.Y.; Islam, S.; Islam, M.R. Flavonoids a Bioactive Compound from Medicinal Plants and Its Therapeutic Applications. BioMed Res. Int. 2022, 2022, 5445291. [Google Scholar] [CrossRef] [PubMed]
- Hwanhlem, N.; Salaipeth, L.; Charoensook, R.; Kanjan, P.; Maneerat, S. Lactic Acid Bacteria from Gamecock and Goat Originating from Phitsanulok, Thailand: Isolation, Identification, Technological Properties and Probiotic Potential. J. Microbiol. Biotechnol. 2022, 32, 355–364. [Google Scholar] [CrossRef] [PubMed]
- Tharmaraj, N.; Shah, N.P. Antimicrobial Effects of Probiotic Bacteria against Selected Species of Yeasts and Moulds in Cheese-based Dips. Int. J. Food Sci. Tech. 2009, 44, 1916–1926. [Google Scholar] [CrossRef]
- Tirado-Kulieva, V.; Quijano-Jara, C.; Avila-George, H.; Castro, W. Predicting the Evolution of pH and Total Soluble Solids during Coffee Fermentation Using Near-Infrared Spectroscopy Coupled with Chemometrics. Curr. Res. Food Sci. 2024, 9, 100788. [Google Scholar] [CrossRef]
- Sanders, E.R. Aseptic Laboratory Techniques: Plating Methods. JoVE 2012, 63, 3064. [Google Scholar] [CrossRef]
- Mitsuwan, W.; Romyasamit, C.; Kimseng, R.; Mahawan, T.; Vimon, S. Eco-Friendly Microencapsulation of Lacticaseibacillus Paracasei Using Ficus Pumila Seed Extract: A Novel Plant-Based Delivery System Enhancing Probiotic Stability and Gastrointestinal Tolerance. Vet. World 2025, 18, 2039–2050. [Google Scholar] [CrossRef]
- Poudel, K.P.; Temesgen, H. Methods for Estimating Aboveground Biomass and Its Components for Douglas-Fir and Lodgepole Pine Trees. Can. J. For. Res. 2016, 46, 77–87. [Google Scholar] [CrossRef]
- Azarpazhooh, E.; Sharayei, P.; Rui, X.; Gharibi-Tehrani, M.; Ramaswamy, H.S. Optimization of Wall Material of Freeze-Dried High-Bioactive Microcapsules with Yellow Onion Rejects Using Simplex Centroid Mixture Design Approach Based on Whey Protein Isolate, Pectin, and Sodium Caseinate as Incorporated Variables. Molecules 2022, 27, 8509. [Google Scholar] [CrossRef]
- Dumitru, M.; Sorescu, I.; Habeanu, M.; Tabuc, C.; Idriceanu, L.; Jurcoane, S. Preliminary Characterisation of Bacillus subtilis Strain Use as a Dietary Probiotic Bio-Additive in Weaning Piglet. Food Feed. Res. 2018, 45, 203–211. [Google Scholar] [CrossRef]
- Ding, H.; Li, B.; Boiarkina, I.; Wilson, D.I.; Yu, W.; Young, B.R. Effects of Morphology on the Bulk Density of Instant Whole Milk Powder. Foods 2020, 9, 1024. [Google Scholar] [CrossRef] [PubMed]
- Milovanovic, B.; Djekic, I.; Miocinovic, J.; Djordjevic, V.; Lorenzo, J.M.; Barba, F.J.; Mörlein, D.; Tomasevic, I. What Is the Color of Milk and Dairy Products and How Is It Measured? Foods 2020, 9, 1629. [Google Scholar] [CrossRef] [PubMed]
- Gregório, M.; Araújo, M.; Albuquerque, A.; Rodrigues, T.; Santos, N.C.; Fonseca, M.T.; Costa, M.E.D.; Tomé, A.; Gomes, J.; Gouveia, D.; et al. Probiotication of Plum Pulp and Conditions Effects Freeze-Drying in Cell Viability, Functional Properties and Antioxidant Activity. Foods 2024, 13, 3551. [Google Scholar] [CrossRef] [PubMed]
- Gbassi, G.K.; Vandamme, T. Probiotic Encapsulation Technology: From Microencapsulation to Release into the Gut. Pharmaceutics 2012, 4, 149–163. [Google Scholar] [CrossRef]
- Jiang, J.; Park, N.J.; Hu, S.; Wong, D.T. A Universal Pre-Analytic Solution for Concurrent Stabilization of Salivary Proteins, RNA and DNA at Ambient Temperature. Arch. Oral Biol. 2009, 54, 268–273. [Google Scholar] [CrossRef]
- Yosboonruang, A.; Ontawong, A.; Thapmamang, J.; Duangjai, A. Antibacterial Activity of Coffea robusta Leaf Extract against Foodborne Pathogens. J. Microbiol. Biotechnol. 2022, 32, 1003–1010. [Google Scholar] [CrossRef]
- Parvekar, P.; Palaskar, J.; Metgud, S.; Maria, R.; Dutta, S. The Minimum Inhibitory Concentration (MIC) and Minimum Bactericidal Concentration (MBC) of Silver Nanoparticles against Staphylococcus aureus. Biomater. Investig. Dent. 2020, 7, 105–109. [Google Scholar] [CrossRef]
- JAMOVI. The Jamovi Project (Version 2.3) [Computer Software]. Available online: https://www.jamovi.org (accessed on 5 May 2025).
- Sun, Q.; Yin, S.; He, Y.; Cao, Y.; Jiang, C. Biomaterials and Encapsulation Techniques for Probiotics: Current Status and Future Prospects in Biomedical Applications. Nanomaterials 2023, 13, 2185. [Google Scholar] [CrossRef]
- Yang, X.; Hong, J.; Wang, L.; Cai, C.; Mo, H.; Wang, J.; Fang, X.; Liao, Z. Effect of Lactic Acid Bacteria Fermentation on Plant-Based Products. Fermentation 2024, 10, 48. [Google Scholar] [CrossRef]
- Xu, H.; Guan, Y.; Shan, C.; Xiao, W.; Wu, M. Development of Thermoultrasound Assisted Blanching to Improve Enzyme Inactivation Efficiency, Drying Characteristics, Energy Consumption, and Physiochemical Properties of Sweet Potatoes. Ultrason. Sonochemistry 2023, 101, 106670. [Google Scholar] [CrossRef]
- Akomea-Frempong, S.; Skonberg, D.I.; Camire, M.E.; Perry, J.J. Impact of Blanching, Freezing, and Fermentation on Physicochemical, Microbial, and Sensory Quality of Sugar Kelp (Saccharina latissima). Foods 2021, 10, 2258. [Google Scholar] [CrossRef]
- Hamid, M.H.A.; Md Yusoff, M.H.; Rosazlina, R.; Shafie, M.H. A Review on Moringa oleifera Polysaccharides: Extraction, Purification, Structure-Activity, Bioactivities and Application. Int. J. Biol. Macromol. 2025, 323, 147089. [Google Scholar] [CrossRef]
- Wang, J.; Xie, B.; Sun, Z. Quality Parameters and Bioactive Compound Bioaccessibility Changes in Probiotics Fermented Mango Juice Using Ultraviolet-Assisted Ultrasonic Pre-Treatment during Cold Storage. LWT 2021, 137, 110438. [Google Scholar] [CrossRef]
- Eadmusik, S.; Phungamngoen, C.; Choosuk, N. Kinetic Degradation of Total Phenolic Content, DPPH Radical Scavenging and Xanthine Oxidase Inhibitory Activities in Yanang (Tiliacora triandra) Leaf Extract During Preparation Process. Malays. J. Anal. Sci. 2019, 23, 516–523. [Google Scholar] [CrossRef]
- Bibi, T.; Liaqat, A.; Mehmood, T.; Iqbal, R.; Nadeem, M.; Hussain, A.; Saeed, F.; Afzaal, M.; Athawab, S.A.; Mugabi, R.; et al. Combined Effect of Thermosonication and Natural Preservatives on the Quality of Sugarcane Juice. Food Chem. X 2025, 29, 102861. [Google Scholar] [CrossRef] [PubMed]
- You, S.; Ma, Y.; Yan, B.; Pei, W.; Wu, Q.; Ding, C.; Huang, C. The Promotion Mechanism of Prebiotics for Probiotics: A Review. Front. Nutr. 2022, 9, 1000517. [Google Scholar] [CrossRef]
- Todorov, S.D.; Dioso, C.M.; Liong, M.-T.; Nero, L.A.; Khosravi-Darani, K.; Ivanova, I.V. Beneficial Features of Pediococcus: From Starter Cultures and Inhibitory Activities to Probiotic Benefits. World J. Microbiol. Biotechnol. 2023, 39, 4. [Google Scholar] [CrossRef]
- Milutinović, M.; Dimitrijević-Branković, S.; Rajilić-Stojanović, M. Plant Extracts Rich in Polyphenols as Potent Modulators in the Growth of Probiotic and Pathogenic Intestinal Microorganisms. Front. Nutr. 2021, 8, 688843. [Google Scholar] [CrossRef]
- Pau, S.; Tan, L.C.; Arriaga, S.; Lens, P.N.L. Lactic Acid Fermentation of Food Waste in a Semicontinuous SBR System: Influence of the Influent Composition and Hydraulic Retention Time. Environ. Technol. 2024, 45, 2993–3003. [Google Scholar] [CrossRef]
- Li, Q.; Zhang, Y.; Wang, C.; Zhang, X.; Wei, R.; Li, Y.; Li, Q.; Xu, N. Comparative Study on the Fermentation Characteristics of Selective Lactic Acid Bacteria in Shanxi Aged Vinegar: Pure Culture Versus Co-Culture. Foods 2024, 13, 3374. [Google Scholar] [CrossRef]
- Bernal-Castro, C.; Espinosa-Poveda, E.; Gutiérrez-Cortés, C.; Díaz-Moreno, C. Vegetable Substrates as an Alternative for the Inclusion of Lactic Acid Bacteria with Probiotic Potential in Food Matrices. J. Food Sci. Technol. 2024, 61, 833–846. [Google Scholar] [CrossRef] [PubMed]
- Rodrigues, F.J.; Cedran, M.F.; Bicas, J.L.; Sato, H.H. Encapsulated Probiotic Cells: Relevant Techniques, Natural Sources as Encapsulating Materials and Food Applications—A Narrative Review. Food Res. Int. 2020, 137, 109682. [Google Scholar] [CrossRef] [PubMed]
- Ceja-Medina, L.I.; Ortiz-Basurto, R.I.; Medina-Torres, L.; Calderas, F.; Bernad-Bernad, M.J.; González-Laredo, R.F.; Ragazzo-Sánchez, J.A.; Calderón-Santoyo, M.; González-Ávila, M.; Andrade-González, I.; et al. Microencapsulation of Lactobacillus plantarum by spray drying with mixtures of Aloe vera mucilage and agave fructans as wall materials. J. Food Process Eng. 2020, 43, e13436. [Google Scholar] [CrossRef]
- Bustamante, M.; Villarroel, M.; Rubilar, M.; Shene, C. Lactobacillus acidophilus La-05 encapsulated by spray drying: Effect of mucilage and protein from flaxseed (Linum usitatissimum L.). LWT—Food Sci. Technol. 2015, 62, 1162–1168. [Google Scholar] [CrossRef]
- Bustamante, M.; Oomah, B.D.; Rubilar, M.; Shene, C. Effective Lactobacillus plantarum and Bifidobacterium infantis encapsulation with chia seed (Salvia hispanica L.) and flaxseed (Linum usitatissimum L.) mucilage and soluble protein by spray drying. Food Chem. 2017, 216, 97–105. [Google Scholar] [CrossRef]
- Sawangwan, T.; Kajadman, D.; Kulchananimit, R. Determination of Prebiotic Properties of Rice Bran Extract. Biosci. Microbiota Food Health 2024, 43, 222–226. [Google Scholar] [CrossRef]
- Demirci, T.; Aktaş, K.; Sözeri, D.; Öztürk, H.İ.; Akın, N. Rice Bran Improve Probiotic Viability in Yoghurt and Provide Added Antioxidative Benefits. J. Funct. Foods 2017, 36, 396–403. [Google Scholar] [CrossRef]
- Lee, J.; Ji, Y.R.; Cho, Y.; Choi, M.-J. Effects of Lyoprotectant and Encapsulated Lactobacillus acidophilus KBL409 on Freeze-Drying and Storage Stability. LWT 2023, 182, 114846. [Google Scholar] [CrossRef]
- Wang, J.; Wu, P.; Dhital, S.; Yu, A.; Chen, X.D. Impact of Freezing and Freeze Drying on Lactobacillus rhamnosus GG Survival: Mechanisms of Cell Damage and the Role of Pre-Freezing Conditions and Cryoprotectants. Foods 2025, 14, 1817. [Google Scholar] [CrossRef]
- Chen, P.; Tan, W.; Cheng, H.; Chen, S.; Ye, X.; Chen, J. The Protective Effect of Freezing Temperatures on Different Lactic Acid Bacteria and Its Mechanism. LWT 2025, 215, 117226. [Google Scholar] [CrossRef]
- Qiao, Y.; Qiu, Z.; Tian, F.; Yu, L.; Zhao, J.; Zhang, H.; Zhai, Q.; Chen, W. Effect of bacteriocin-producing Pediococcus acidilactici strains on the immune system and intestinal flora of normal mice. Food Sci. Hum. Wellness 2022, 11, 238–246. [Google Scholar] [CrossRef]
- Latif, A.; Shehzad, A.; Niazi, S.; Zahid, A.; Ashraf, W.; Iqbal, M.W.; Rehman, A.; Riaz, T.; Aadil, R.M.; Khan, I.M.; et al. Probiotics: Mechanism of Action, Health Benefits and Their Application in Food Industries. Front. Microbiol. 2023, 14, 1216674. [Google Scholar] [CrossRef]
- Buahom, J.; Siripornadulsil, S.; Sukon, P.; Sooksawat, T.; Siripornadulsil, W. Survivability of Freeze- and Spray-Dried Probiotics and Their Effects on the Growth and Health Performance of Broilers. Vet. World 2023, 16, 1849–1865. [Google Scholar] [CrossRef]

| Extraction Conditions | pH | TSS (°Brix) | Viable Count (Log CFU/mL) | ||
|---|---|---|---|---|---|
| PCA (P) | MRS Agar (M) | P–M | |||
| Freezing process | |||||
| Unfrozen | 4.52 A | 1.98 | 8.15 B | 7.89 B | 0.31 |
| Frozen at −20 °C | 4.35 B | 2.01 | 8.23 A | 8.05 A | 0.19 |
| SEM | 0.086 | 0.021 | 0.012 | 0.046 | 0.091 |
| p-value | <0.001 | 0.363 | 0.001 | 0.001 | 0.216 |
| Blanching process | |||||
| Unblanched | 4.65 a | 2.10 | 7.89 B | 7.63 B | 0.26 |
| Blanched for 2 min with hot water | 4.54 b | 2.11 | 8.12 A | 8.10 A | 0.02 |
| SEM | 0.092 | 0.021 | 0.090 | 0.010 | 0.001 |
| p-value | 0.014 | 0.496 | 0.001 | 0.001 | 0.001 |
| Preparation process | |||||
| Unfrozen and unblanched leaves | 4.75 a | 1.99 | 8.20 b | 8.13 b | 0.06 |
| Frozen and unblenched leaves | 4.59 b | 2.02 | 8.20 b | 8.13 b | 0.07 |
| Frozen then blanched leaves | 4.70 b | 2.00 | 8.24 a | 8.23 a | 0.02 |
| Blanched and unfrozen leaves | 4.65 b | 1.99 | 8.12 c | 8.10 c | 0.03 |
| Blanched then frozen leaves | 4.80 a | 2.02 | 8.14 c | 8.09 c | 0.05 |
| SEM | 0.069 | 0.018 | 0.011 | 0.012 | 0.004 |
| p-value | 0.039 | 0.567 | 0.025 | 0.019 | 0.057 |
| Water temperature | |||||
| Cool temperature at 4 °C | 4.65 a | 1.99 | 8.12 | 8.00 a | 0.18 b |
| Room temperature at 25 °C | 4.59 a | 2.02 | 8.16 | 8.06 a | 0.11 b |
| Hot temperature at 100 °C | 4.90 b | 2.00 | 8.10 | 7.89 b | 0.22 a |
| SEM | 0.062 | 0.039 | 0.05 | 0.05 | 0.028 |
| p-value | 0.025 | 0.612 | 0.43 | 0.001 | 0.024 |
| Yanang leaves: water ratio (w/v) | |||||
| 1:3 | 4.65 b | 2.10 | 8.14 | 8.10 a | 0.18 b |
| 1:4 | 4.90 a | 2.02 | 8.01 | 7.91 b | 0.11 b |
| 1:5 | 4.90 a | 2.01 | 8.00 | 7.82 b | 0.22 a |
| SEM | 0.062 | 0.021 | 0.079 | 0.028 | 0.014 |
| p-value | 0.025 | 0.427 | 0.434 | 0.019 | 0.024 |
| Sterilization process | |||||
| Non-sterilization | 4.61 B | 1.97 | 8.36 B | 8.29 B | 0.08 |
| Pasteurization at 75 °C, 5 min | 4.27 C | 2.03 | 8.79 A | 8.66 A | 0.13 |
| Steam sterilization at 100 °C, 10 min | 4.86 A | 1.97 | 8.49 B | 8.58 A | −0.10 |
| Autoclavation at 121 °C, 15 min | 5.07 A | 2.00 | 8.27 B | 8.22 B | 0.05 |
| SEM | 0.093 | 0.001 | 0.063 | 0.061 | 0.046 |
| p-value | <0.001 | 0.363 | 0.007 | 0.007 | 0.374 |
| Probiotic Strains | pH | TSS (°Brix) | Viable Count (Log CFU/mL) | ||
|---|---|---|---|---|---|
| PCA (P) | Selective Agar (S) | P–S | |||
| P. acidilactici V202 | 4.02 B | 2.07 AB | 8.79 A | 8.66 A | 0.13 |
| L. plantarum TISTR 926 | 4.06 B | 2.10 A | 8.67 A | 8.59 A | 0.08 |
| S. thermophilus TISTR 894 | 4.01 B | 2.00 BC | 8.69 A | 8.56 A | 0.13 |
| B. subtilis RP4-18 | 5.19 A | 1.97 C | 8.49 B | 8.34 B | 0.15 |
| B. licheniformis 46-2 | 5.11 A | 2.00 BC | 8.46 B | 8.26 B | 0.19 |
| SEM | 0.147 | 0.015 | 0.040 | 0.043 | 0.020 |
| p-value | <0.001 | 0.007 | 0.009 | <0.001 | 0.511 |
| Freeze-Dried Probiotic Products | Freeze-Drying Efficiency | Aw | Bulk Density (g/100 mL) | Tapped Density (g/100 mL) | Compressibility of Powder Ratio (%) | |
|---|---|---|---|---|---|---|
| Product Yield (%) | Viability (%) | |||||
| P. acidilactici V202 | 20.22 | 96.71 | 0.20 | 24.33 | 28.33 | 14.12 |
| L. plantarum TISTR 926 | 19.93 | 95.94 | 0.20 | 24.67 | 29.00 | 14.87 |
| S. thermophilus TISTR 894 | 20.18 | 96.70 | 0.20 | 24.67 | 29.33 | 15.90 |
| B. subtilis RP4-18 | 20.24 | 94.18 | 0.19 | 25.00 | 29.33 | 14.76 |
| B. licheniformis 46-2 | 20.18 | 94.16 | 0.19 | 24.00 | 28.33 | 15.27 |
| SEM | 0.130 | 0.223 | 0.001 | 0.165 | 0.215 | 0.488 |
| p-value | 0.96 | 0.054 | 0.511 | 0.415 | 0.388 | 0.878 |
| Item | MIC/MBC (%v/v) | |||
|---|---|---|---|---|
| B. cereus WU22001 | S. aureus ATCC25923 | E. coli ATCC 25922 | S. Typhimurium WU241001 | |
| P. acidilactici V202 | 50/>50 | 25/>50 | 25/>50 | 50/>50 |
| L. plantarum TISTR 926 | 50/>50 | 50/>50 | 25/>50 | 50/>50 |
| S. thermophilus TISTR 894 | 50/>50 | 50/>50 | 25/>50 | 50/>50 |
| B. subtilis RP4-18 | 50/>50 | 50/>50 | 50/>50 | 50/>50 |
| B. licheniformis 46-2 | 50/>50 | 50/>50 | 50/>50 | 50/>50 |
| Vancomycin, µg/mL | 1/2 | 0.5/1 | NA | NA |
| Gentamicin, µg/mL | NA | NA | 0.5/1 | 1/1 |
Disclaimer/Publisher’s Note: The statements, opinions and data contained in all publications are solely those of the individual author(s) and contributor(s) and not of MDPI and/or the editor(s). MDPI and/or the editor(s) disclaim responsibility for any injury to people or property resulting from any ideas, methods, instructions or products referred to in the content. |
© 2025 by the authors. Licensee MDPI, Basel, Switzerland. This article is an open access article distributed under the terms and conditions of the Creative Commons Attribution (CC BY) license (https://creativecommons.org/licenses/by/4.0/).
Share and Cite
Nopparatmaitree, M.; Incharoen, T.; Mitsuwan, W.; Thongnum, A.; Loor, J.J.; Hwanhlem, N. Optimization of Tiliacora triandra Leaf Extraction and Probiotic Fermentation for Developing a Functional Freeze-Dried Feed Supplements. Fermentation 2025, 11, 602. https://doi.org/10.3390/fermentation11100602
Nopparatmaitree M, Incharoen T, Mitsuwan W, Thongnum A, Loor JJ, Hwanhlem N. Optimization of Tiliacora triandra Leaf Extraction and Probiotic Fermentation for Developing a Functional Freeze-Dried Feed Supplements. Fermentation. 2025; 11(10):602. https://doi.org/10.3390/fermentation11100602
Chicago/Turabian StyleNopparatmaitree, Manatsanun, Tossaporn Incharoen, Watcharapong Mitsuwan, Atichat Thongnum, Juan J. Loor, and Noraphat Hwanhlem. 2025. "Optimization of Tiliacora triandra Leaf Extraction and Probiotic Fermentation for Developing a Functional Freeze-Dried Feed Supplements" Fermentation 11, no. 10: 602. https://doi.org/10.3390/fermentation11100602
APA StyleNopparatmaitree, M., Incharoen, T., Mitsuwan, W., Thongnum, A., Loor, J. J., & Hwanhlem, N. (2025). Optimization of Tiliacora triandra Leaf Extraction and Probiotic Fermentation for Developing a Functional Freeze-Dried Feed Supplements. Fermentation, 11(10), 602. https://doi.org/10.3390/fermentation11100602

